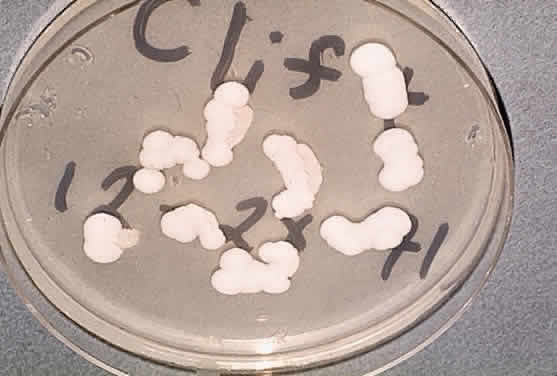

TUBERCULOSIS
Mycobacterium tuberculosis is a facultative, intracellular, aerobic, acid-fast bacillus that is pathogenic only for humans. It produces mainly lung disease, but many extrapulmonary sites, including the eye, can also be affected. Cellular rather than humoral immune mechanisms are decisive in the host's recovery from tuberculosis, and in its diagnosis the tuberculin skin test (a manifestation of cellular immunity) is more useful than the measurement of serum antibody.
Immunopathology
M. tuberculosis can survive and proliferate within phagocytic cells. It may escape the bactericidal effect of the macrophages by preventing the fusion of enzyme-containing lysosomes with phagosomes that contain the organisms. Lipids and waxes of high molecular weight constitute up to 60% of the bacterium's cell wall and may be responsible for the responses of the host's tissues to the tubercle bacillus. They may also account for the impermeability of the organism to tissue stains. Tuberculoproteins are responsible for the induction of hypersensitivity and for the reaction of the skin to tuberculin. A substance known as “cord factor” causes the serpentine growth of the tubercle bacillus and may also inhibit leukocyte migration and stimulate granuloma formation.
The host deals with M. tuberculosis principally by the mechanism of cellular immunity. Cell-mediated immunity to tuberculin can be passively transferred to uninfected experimental animals along with living lymphoid cells but not with immune serum. Immunity can also be transferred with the leukocyte extract transfer factor. Although patients with agammaglobulinemia produce no demonstrable antibodies, they can develop delayed hypersensitivity responses and normal resistance to the tubercle bacillus. Patients with defects in delayed hypersensitivity are more susceptible to the disease than persons normal in this respect.
Tuberculosis may affect nearly all of the ocular tissues. A granulomatous uveitis is the lesion most frequently encountered and may be associated with mutton-fat keratic precipitates, Koeppe nodules, and vitreous opacities. Diffuse posterior uveitis may also occur, and although rare with modern treatment, the disease can affect the lids, sclera, cornea, and retina. With the recent increase in tuberculosis in AIDS patients, the ocular manifestations of tuberculosis are increasing.1–3
LEPROSY
Leprosy is a chronic infectious disease caused by Mycobacterium leprae, an obligate, intracellular, acid-fast bacillus (Fig. 1). This organism can invade nerves and skin and give rise to widespread clinical manifestations. Ocular lesions occur in 90% of lepromatous leprosy cases, and nearly one third of these produce significant visual loss.
|
Immunopathology
The following three clinical types of leprosy are recognized: (1) lepromatous (nodular) leprosy is characterized by marked deficiency in cellular immunity and extensive infiltration of the tissues with M. leprae, (2) tuberculoid leprosy is distinguished by the preservation of immune responses and the absence of demonstrable bacilli within the tissues, and (3) intermediate or borderline leprosy has features of both the lepromatous and tuberculoid types. Patients with lepromatous leprosy are anergic to the lepromin skin test antigen, to which normal persons have a positive delayed hypersensitivity reaction. They also fail to develop contact allergy to dinitrochlorobenzene (DNCB) and other contact sensitizers, they have depressed delayed hypersensitivity reactions to common bacterial antigens, and they demonstrate prolonged skin allograft survival.4,5
Patients with lepromatous leprosy have significantly lower-than-normal levels of circulating T and B lymphocytes, and the T cells in the paracortical regions of their lymph nodes are severely depleted.6 Their peripheral lymphocytes show diminished blast transformation in the presence of the mitogen phytohemagglutinin. Animals thymectomized at birth, and therefore lacking cellular immunity, readily develop widespread infections with M. leprae.7 The infection is apparently related to the survival of the bacillus within macrophages. Recent electron microscopic studies have shown that the organism can escape from the phagolysosome and remain free in the macrophage cytoplasm.
In contrast to being deficient in cellular immunity, patients with lepromatous leprosy produce normal or greater-than-normal numbers of antibodies and may even produce autoantibodies. They have above-normal levels of both gamma globulin and the cryoproteins. Thyroglobulin antibodies and rheumatoid factor are found in 50% of patients and false-positive Venereal Disease Research Laboratory (VDRL) tests in about 10%. Lupus erythematosus (LE) cells occasionally appear, and antibodies to both basement membrane and intercellular substances have been found in the skin of infected patients. The similarity between leprosy and the collagen vascular diseases, particularly LE, is indicated by their sharing such clinical manifestations as butterfly facial rashes, arthritis, depressed cellular immunity, and autoantibody production.
In lepromatous leprosy, the lids may show granulomatous inflammation,8 and nodules may appear on the face and eyelids. A hyperemic conjunctivitis may develop and may be followed by symblepharon and lid deformities. Corneal nodules, interstitial keratitis, iridocyclitis, and chorioretinitis have also been reported.9
Diagnosis
The lepromin skin test was introduced by Mitsuda and is performed with extracts of skin nodules from leprosy patients. A positive intradermal test leads to a tuberculin type of skin reaction 24 to 48 hours later, and a nodular reaction (the Mitsuda reaction) appears in about 7 days and peaks in 3 or 4 weeks. The test is useful in differentiating the types of leprosy in patients already known to have the disease. A positive lepromin skin test indicates tuberculoid or nearly tuberculoid disease, and a negative skin test indicates progression to lepromatous leprosy. Positive skin tests are common in the normal population due to cross-reactivity with other mycobacterial antigens.
SYPHILIS
Syphilis is caused by the spirochete Treponema pallidum, a motile, highly infectious agent that functions predominantly as an extracellular pathogen. It occurs naturally only in humans and is most easily transmitted by sexual contact. Both humoral and cellular immunity are important in the defense of the host against syphilis. Three stages of the diseases are clinically identifiable, and the eye may be involved in all three. Although severe, destructive syphilitic lesions have been far less common since the discovery of penicillin, the disease must be considered in the differential diagnosis of many diverse clinical problems.
Immunopathology
Immunity to T. pallidum depends on a complex interaction between humoral and cellular immunity. Several lines of evidence indicate that antibody is important in this infection. Partial immunity develops in the rabbit after the passive transfer of serum from immune animals. Immobilizing antibodies against treponemes can be found in the serum of patients who have had syphilis, especially advanced syphilis. A number of nonspecific or reaginic antibodies are found in the sera of patients who have the disease, and these form the basis of many serologic diagnostic tests. Immune complex deposition may play a role in the nephropathy associated with secondary syphilis in adults, and IgG may be found along the glomerular basement membrane in patients with congenital syphilis.10
Delayed hypersensitivity directed against treponemal antigens is absent in primary and early secondary syphilis, develops late in the secondary disease, and is found regularly in latent and tertiary disease. Because syphilis progresses through the primary and secondary stages despite the presence of antibodies that immobilize treponemes, it follows that antibodies developing during the course of an infection are at best only partially protective.
When viewed microscopically, the typical lesion of syphilis is a granulomatous inflammation. Granulomas, which contain reticuloendothelial cells (including epithelioid and giant cells), are thought to represent an immune response to such poorly soluble substances as foreign bodies, insoluble antigens, and microorganisms that cannot be easily eliminated. Granulomatous reactions are clearly different from typical delayed hypersensitivity reactions: their onset is much slower, and they may require weeks or even months to develop. Many granulomatous lesions are accompanied by vasculitis, suggesting that there may be an associated immune complex disease.
Diagnosis
During primary and secondary syphilis, the spirochete can be identified microscopically by dark-field examination. Serologic tests do not become positive until 14 to 21 days after the initial infection. Because spirochetes are difficult to identify in the late stages of the disease, serologic tests are extremely important. Two categories of tests—for reaginic antibodies and for treponemal antibodies—are available. Reaginic antibodies bear no relation to IgE; rather, they are antibodies directed against cardiolipin, a tissue-derived substance thought to be a component of mitochondrial membranes. Beef heart is used as a source of cardiolipin in many reaginic antibody diagnostic tests, examples of which are the VDRL, Hinton, and Kahn tests. Unfortunately, false-positive results on these tests occur in such diseases as LE, leprosy, infectious mononucleosis, and hepatitis, probably because of the many tissues and microorganisms that have mitochondrial membranes.
Two tests for treponemal antibody are the T. pallidum immobilization test and the fluorescent T. pallidum antibody test (FTA). In the former, specific antibodies against the spirochete can be detected, whereas the latter uses spirochetes from infected rabbit testes as a substrate for the serum being tested. If positive, the bound antibody can be detected with fluoresceinated antihuman gamma globulin. Other nonpathogenic treponemes may be absorbed from the serum before testing, in which case the test is referred to as the FTA absorption test (FTA-ABS test).
The FTA-ABS test is positive in 80% to 100% of primary syphilis cases, the VDRL test in 50% to 70%.11 In secondary syphilis, both tests are nearly always positive. The VDRL test is less often positive after treatment, whereas the FTA-ABS test remains positive for many years; although false-positive VDRL results are common, one rarely encounters a false-positive FTA-ABS result, except in systemic lupus. In latent syphilis, the VDRL test is negative in up to one third of patients.
Treponemes are sometimes detected in the aqueous humor of patients with uveitis, but they may be nonpathogenic organisms such as Treponema microdentium.12 Aqueous humor aspiration, followed by the FTA technique, may be useful when a search for treponemes is being made.
A chancre may occur on the lids or conjunctiva in primary syphilis. A pinkish, macular rash may appear on the lids in secondary syphilis, and ulcerative blepharitis can cause scarring and loss of cilia. Iridocyclitis can occur in secondary syphilis, and chorioretinitis can be associated with late secondary and tertiary disease. Tertiary syphilis can produce distinctive lesions of the eye and central nervous system.
Interstitial keratitis is the hallmark of congenital syphilis and may be a hypersensitivity phenomenon.13 Other features of congenital syphilis are iridocyclitis, chorioretinitis, and malformation of the optic discs. HIV-positive patients may have an atypically dense vitritis14 or other forms of uveitis.15–17
TULAREMIA
Francisella tularensis, the organism that causes tularemia, is a pleomorphic gram-negative coccobacillus that requires special culture media for its isolation. As small a dose as 50 organisms of the more virulent type A form can produce infection in humans. Type B produces a milder disease. Infection is transmitted by intermediate rodent hosts, especially the rabbit. A substantial number of cases have also been reported in association with exposure to ticks. Other intermediate hosts are squirrels, cats, foxes, and raccoons. Tularemia is an occupational hazard for shepherds, mink ranchers, hunters, and butchers, all of whom may handle infected tissues. Purulent conjunctivitis and typical Parinaud's oculoglandular syndrome can follow inoculation of the eye with F. tularensis.
Immunopathology
Although the host's defenses against tularemia are not fully understood, cell-mediated immunity appears to be important. Immunity is associated with (1) a delayed hypersensitivity skin reaction to tularemia skin-test antigen, and (2) the greater-than-normal ability of rabbit macrophages to kill F. tularensis. In vitro tests for cell-mediated immunity are present in sensitized individuals. Inactivated vaccines have no protective effect, but a live, attenuated strain of the organism can protect both humans and animals. There is no evidence that antibodies are protective in tularemia.
Diagnosis
Diagnosis is based on isolation of the organisms and a rise in agglutinating antibody titers, which usually occurs after the first 2 weeks of illness but may take much longer. In most cases there is a fourfold or greater rise. A skin test, in which a lyophilized, ether-extracted bacterial antigen is used, may be helpful but is not always available.
BRUCELLOSIS
This is an infection acquired by humans through contact with infected tissue of cattle, pigs, sheep, and goats, or by ingestion of raw milk or milk byproducts. It is one of the most prevalent zoonoses in the Unites States and is caused by several species of the genus Brucella, a small gram-negative bacillus. The causal species are B. abortus, B. melitensis, B. suis, and rarely B. canis. Veterinarians and abattoir workers are often intermediate hosts. The organism is transmitted from infected tissues to humans through cuts in the skin, conjunctival contact, ingestion of uncooked meat, or inhalation of organisms. The ocular lesions associated with Brucella infection are nummular keratitis, scleritis, optic neuritis, and uveitis.
Immunopathology
Brucella has a predilection for the reticuloendothelial system. Once ingested, the organisms are rapidly taken up by neutrophils and transported to the histiocytes of the liver, spleen, and lymph nodes. There they enter a period of prolonged intracellular residence. They may remain intracellular for several weeks (rarely for months) while the phagocytes containing the organisms form noncaseating granulomas. Clinical symptoms occur when organisms are released from infected reticuloendothelial cells.
Immunity to Brucella seems to be cell-mediated. Delayed hypersensitivity develops during experimental infection. The skin test lacks specificity, however, and has been discontinued for routine use in the United States.
Although antibodies in Brucella infection are not protective, agglutinating and complement-fixing antibodies can be measured. An IgA antibody can act as a blocking factor and produce spuriously low agglutinin levels, but interference by this factor can be avoided by using a Coombs' test. Antibody measurement is important in the diagnosis of brucellosis, because the organism is fastidious and culture is difficult.
LYME DISEASE
Lyme disease is caused by the spirochete Borrelia burgdorferi and is transmitted by the deer tick.18,19 Systemic findings include a purpuric skin rash, “target” lesions, and sudden onset of arthritis involving the knees and ankle joints. Serologic and immunofluorescent tests are available for identifying the infection. Ocular findings include chronic intermediate uveitis,20 posterior uveitis,21 choriocapillaritis, neuroretinitis, retinal vasculitis, multifocal corneal infiltrates, and conjunctivitis.22,23 Treatment with antibodies, such as ceftriaxone, and steroids is generally indicated.24